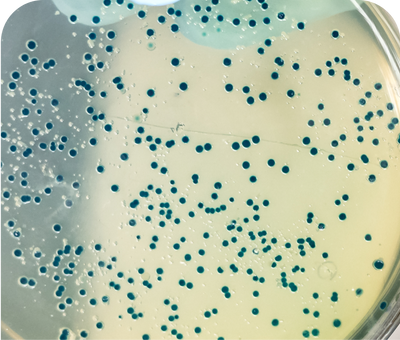
oral health postbiotic for dogs

With Plentum, we didn't want to just mask the problem. We wanted to solve it. Our approach targets the oral microbiome to stop bad breath at the source, while simultaneously supporting joints, gut, and immunity. It's an easy, effective upgrade for any pup.
Dr. Sarah Miller
DVM, PhD,
Board Certified Veterinary Nutritionist
Dog Oral Health Supplements

80%
of dogs suffer from periodontal disease by age 2.

Don't ignore the stink. Bad breath is often the first sign of bacterial imbalance.
Proven Science. Fresher Breath.
98%
Reduction in Oral Biofilms
Destroys the sticky plaque layer where bad bacteria hide and breed.
7 Days
to noticeable results.
Clinically proven to reduce malodor scores in just one week.
85%
Fewer Odor Compounds
Neutralizes the Volatile Sulfur Compounds (VSCs) that cause the stink.
The Experts Behind the Science


Science-Backed Ingredients
Canine Oral Health Postbiotic
Promotes healthy oral microbiome & breath.

Colostrum
Immune function & gut health.

Inulin (Prebiotic)
Prebiotic; supports digestive health.
Advanced K9 Microbiome Care
Supports dogs at every stage from energetic puppies to seniors needing extra care.
This depends on the weight of your dog.
Up to 20 lbs: 1 sachet daily
20-50 lbs: 2 sachets daily
Above 50 lbs: 3 sachets daily
9 active ingredients - clean label and active doses listed for transparency, as validated by the clinical studies behind our formula.
- Use the recommended number of sachet based on your dog’s weight. (Refer to detailed guide here)
- Sprinkle over your dog’s food and mix well.
- Serve and see them enjoy the gut-friendly goodness.
Dental Care That Goes Deeper
Backed by clinical trials
Contains Patent-Pending Postbiotic
100% Active Ingredients
Complete all-in-one nutrition













































